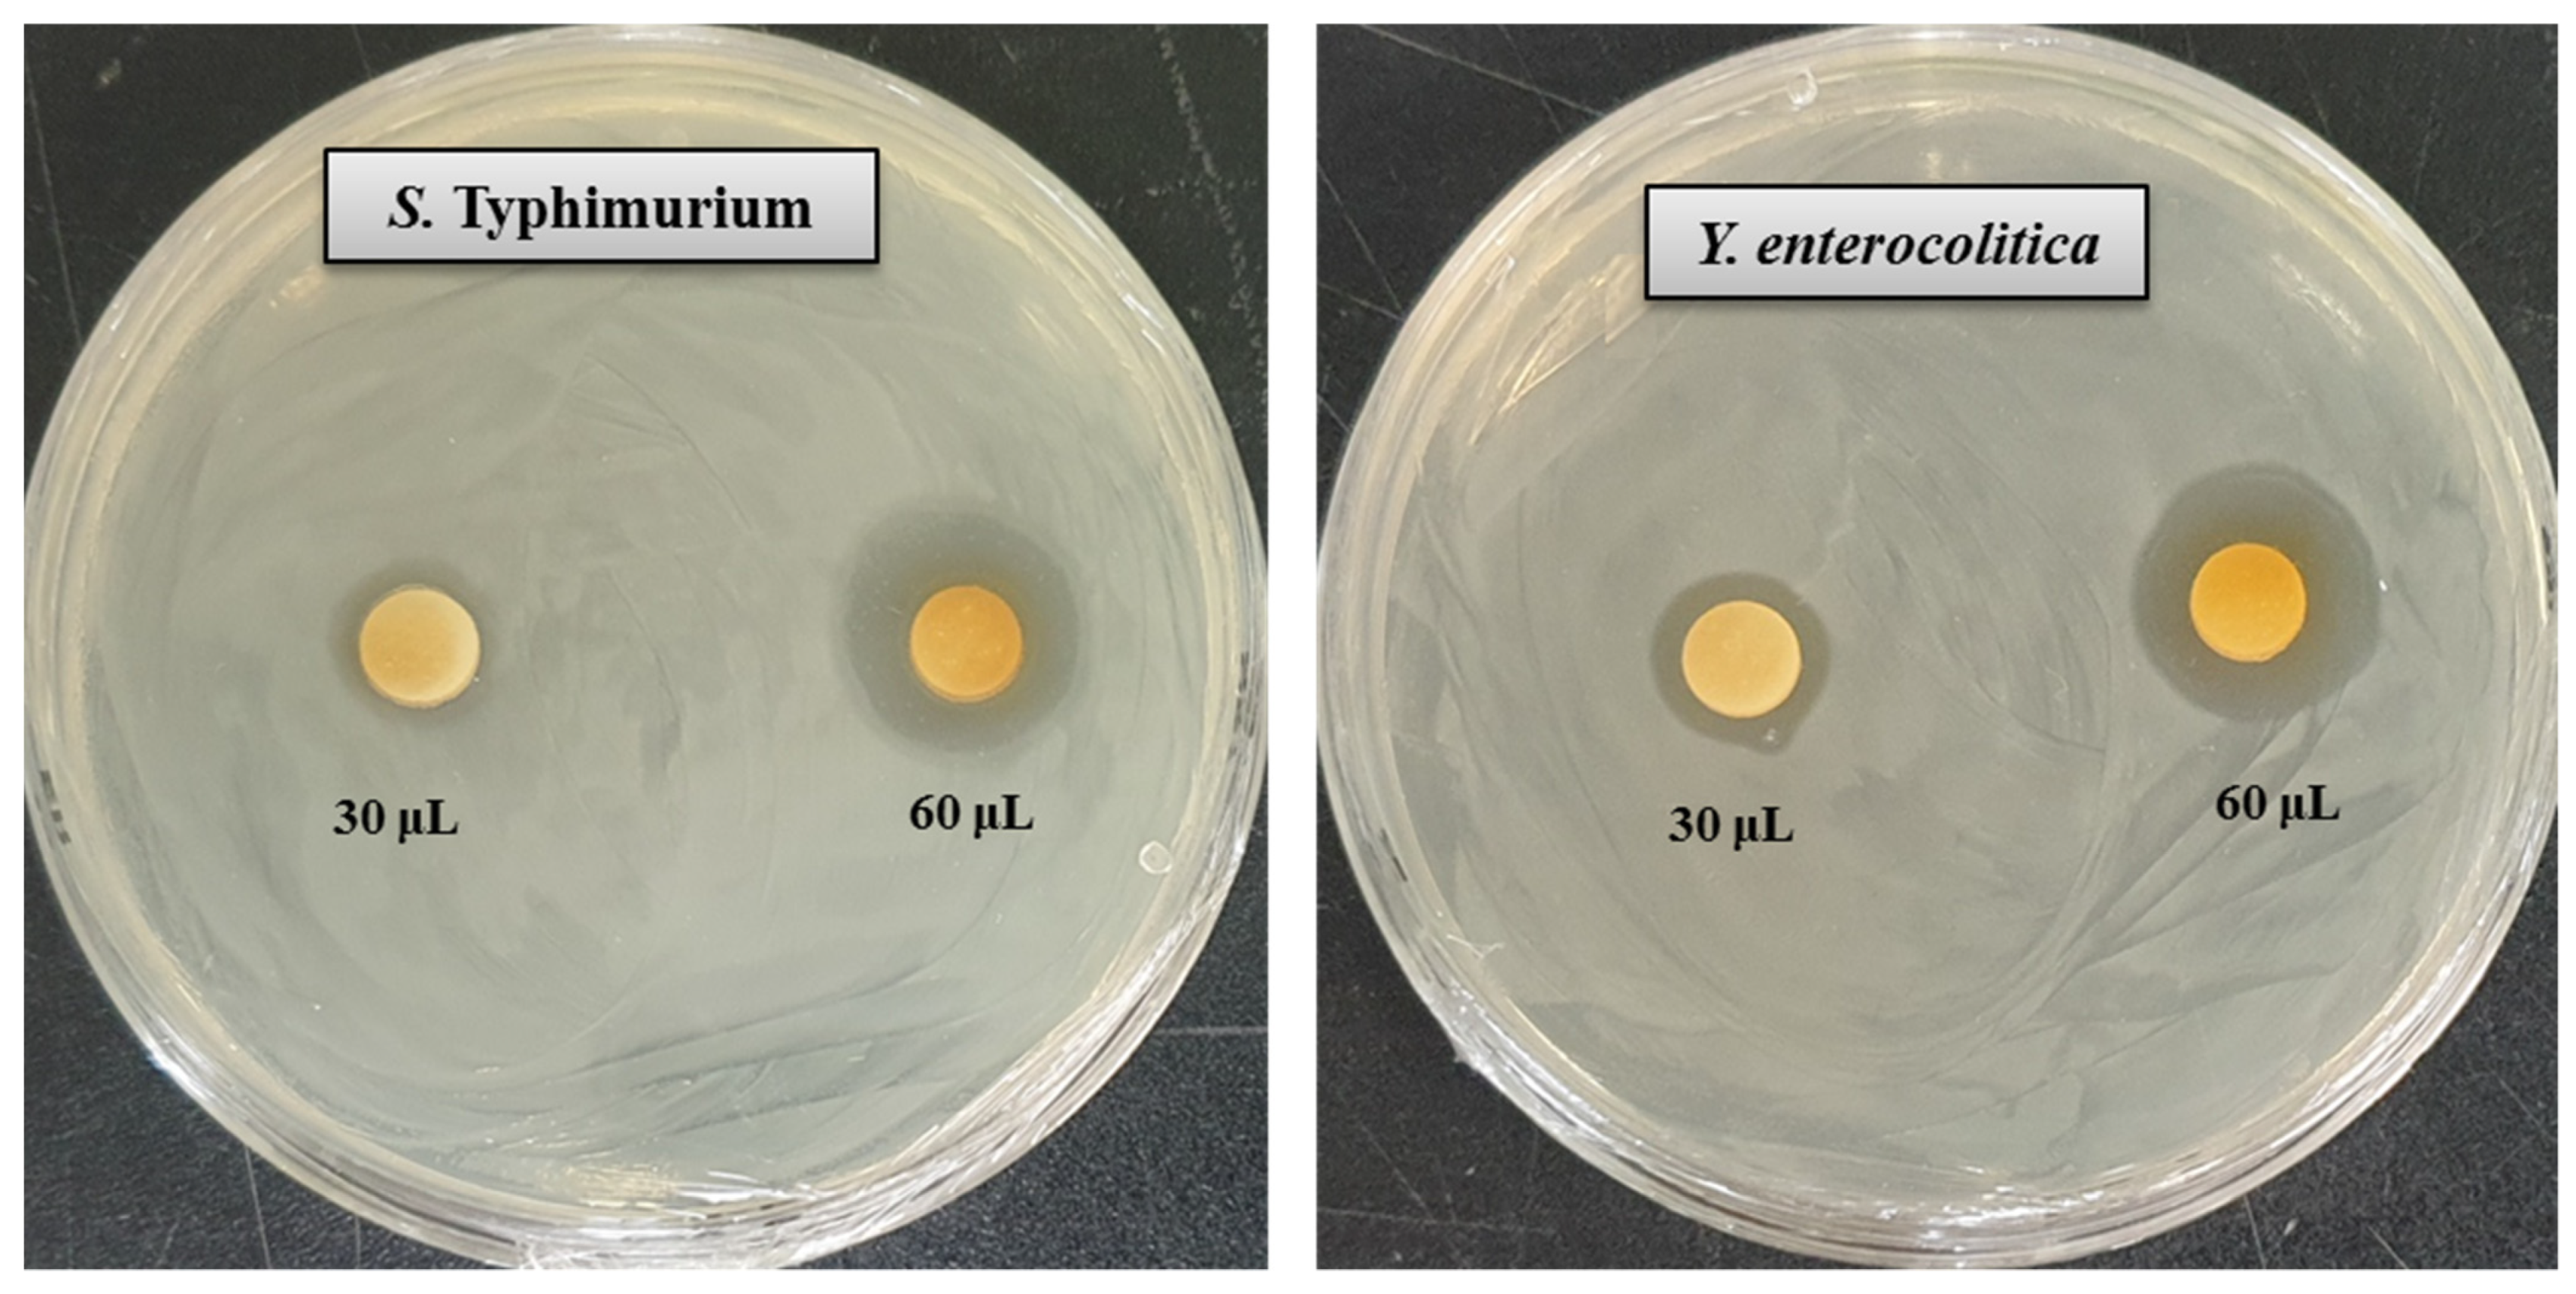
Pharmaceutics 13 01691 g007 Pharmaceutics 13 01691 g007

Characterization and Genome Analysis of Arthrobacter bangladeshi sp. nov., Applied for the Green Synthesis of Silver Nanoparticles and Their Antibacterial Efficacy against Drug-Resistant Human Pathogens
Abstract
1. Introduction
2. Materials and Methods
2.1. Materials
2.2. Isolation of AgNP-Producing Bacteria
2.3. Phenotypic, Physiological, and Biochemical Characteristics
2.4. 16S rRNA Gene Sequencing and Phylogenetic Analysis
2.5. Genomic Sequence Analysis
2.6. Cellular Fatty Acid and Respiratory Quinones Analysis
2.7. Biosynthesis of AgNPs Using Arthrobacter bangladeshi sp. nov.
2.8. Characterization of Synthesized AgNPs
2.9. Antimicrobial Activity of Synthesized AgNPs
2.10. MIC and MBC Investigation
2.11. Investigation of Morphological Changes by FE-SEM
3. Results and Discussion
3.1. Phenotypic, Physiological, and Biochemical Characteristics
3.2. 16S rRNA Gene Sequence and Phylogenetic Analysis
3.3. Draft Genome and DNA G + C Content Analysis
3.4. Cellular Fatty Acid and Respiratory Quinones Analysis
3.5. Taxonomic Conclusions
3.6. Description of Arthrobacter bangladeshi sp. nov.
3.7. Green Synthesis of AgNPs Using Arthrobacter bangladeshi sp. nov.
3.8. Characterization of Green Synthesized AgNPs
3.9. Antimicrobial Activity of Synthesized AgNPs
3.10. MIC and MBC Investigation
3.11. Investigation of Morphological Changes by FE-SEM
4. Conclusions
Supplementary Materials
Author Contributions
Funding
Institutional Review Board Statement
Informed Consent Statement
Data Availability Statement
Acknowledgments
Conflicts of Interest
References
- Conn, H.J.; Dimmick, I. Soil bacteria similar in morphology to Mycobacterium and Corynebacterium. J. Bacteriol. 1947, 54, 291–303. [Google Scholar] [CrossRef]
- Chen, Y.G.; Tang, S.K.; Zhang, Y.Q.; Li, Z.Y.; Yi, L.B.; Wang, Y.X.; Li, W.J.; Cui, X.L. Arthrobacter halodurans sp. nov., a new halotolerant bacterium isolated from sea water. Antonie Van Leeuwenhoek 2009, 96, 63–70. [Google Scholar] [CrossRef]
- Yan, R.; Liu, D.; Fu, Y.; Zhang, Y.; Ju, H.; Zhao, J.; Wang, X.; Zhang, J.; Xiang, W. Arthrobacter celericrescens sp. nov., isolated from forest soil. Int. J. Syst. Evol. Microbiol. 2019, 69, 3093–3099. [Google Scholar] [CrossRef]
- Krishnan, R.; Menon, R.R.; Tanaka, N.; Busse, H.J.; Krishnamurthi, S.; Rameshkumar, N. Arthrobacter pokkalii sp nov, a Novel Plant Associated Actinobacterium with Plant Beneficial Properties, Isolated from Saline Tolerant Pokkali Rice, Kerala, India. PLoS ONE 2016, 11, e0150322. [Google Scholar] [CrossRef]
- Kim, K.K.; Lee, K.C.; Oh, H.M.; Kim, M.J.; Eom, M.K.; Lee, J.S. Arthrobacter defluvii sp. nov., 4-chlorophenoldegrading bacteria isolated from sewage. Int. J. Syst. Evol. Microbiol. 2008, 58, 1916–1921. [Google Scholar] [CrossRef] [PubMed]
- Ding, L.; Hirose, T.; Yokota, A. Four novel Arthrobacter species isolated from filtration substrate. Int. J. Syst. Evol. Microbiol. 2009, 59, 856–862. [Google Scholar] [CrossRef] [PubMed][Green Version]
- Kallimanis, A.; Kavakiotis, K.; Perisynakis, A.; Spröer, C.; Drainas, C.; Koukkou, A.I. Arthrobacter phenanthrenivorans sp. nov., to accommodate the phenanthrene-degrading bacterium Arthrobacter sp. strain Sphe3. Int. J. Syst. Evol. Microbiol. 2009, 59, 275–279. [Google Scholar] [CrossRef] [PubMed]
- Dastager, S.G.; Qin, L.; Tang, S.K.; Krishnamurthi, S.; Lee, J.C.; Li, W.J. Arthrobacter enclensis sp. nov., isolated from sediment sample. Arch. Microbiol. 2014, 196, 775–782. [Google Scholar] [CrossRef] [PubMed]
- Burdusel, A.C.; Gherasim, O.; Grumezescu, A.M.; Mogoanta, L.; Ficai, A.; Andronescu, E. Biomedical applications of silver nanoparticles: An up-to-date overview. Nanomaterials 2018, 8, 681. [Google Scholar] [CrossRef] [PubMed]
- Rai, M.; Yadav, A.; Gade, A. Silver nanoparticles as a new generation of antimicrobials. Biotechnol. Adv. 2009, 27, 76–83. [Google Scholar] [CrossRef]
- Akter, S.; Huq, M.A. Biologically rapid synthesis of silver nanoparticles by Sphingobium sp. MAH-11T and their antibacterial activity and mechanisms investigation against drug-resistant pathogenic microbes. Artif. Cells Nanomed. Biotechnol. 2020, 48, 672–682. [Google Scholar] [CrossRef]
- Iravani, S.; Korbekandi, H.; Mirmohammadi, S.V.; Zolfaghari, B. Synthesis of silver nanoparticles: Chemical, physical and biological methods. Res. Pharm. Sci. 2014, 9, 385. [Google Scholar]
- Thakkar, K.N.; Mhatre, S.S.; Parikh, R.Y. Biological synthesis of metallic nanoparticles. Nanome. Nanotechnol. Biol. Med. 2010, 6, 257–262. [Google Scholar] [CrossRef]
- Binupriya, A.; Sathishkumar, M.; Yun, S.-I. Biocrystallization of silver and gold ions by inactive cell filtrate of Rhizopus stolonifer. Colloids Surf. B Biointerfaces 2010, 79, 531–534. [Google Scholar] [CrossRef]
- Narayanan, K.B.; Sakthivel, N. Biological synthesis of metal nanoparticles by microbes. Adv. Colloids Interface Sci. 2010, 156, 1–13. [Google Scholar] [CrossRef] [PubMed]
- Li, X.; Xu, H.; Chen, Z.-S.; Chen, G. Biosynthesis of nanoparticles by microorganisms and their applications. J. Nanomater. 2011, 8, 1–16. [Google Scholar] [CrossRef]
- Roy, A.; Bulut, O.; Some, S.; Mandal, A.K.; Yilmaz, M.D. Green synthesis of silver nanoparticles: Biomolecule-nanoparticle organizations targeting antimicrobial activity. RSC Adv. 2019, 9, 2673–2702. [Google Scholar] [CrossRef]
- Huq, M.A. Paenibacillus anseongense sp. nov. a Silver Nanoparticle Producing Bacterium Isolated from Rhizospheric Soil. Curr. Microbiol. 2020, 77, 2023–2030. [Google Scholar] [CrossRef]
- Huq, M.A. Microvirga rosea sp. nov.: A nanoparticle producing bacterium isolated from soil of rose garden. Arch. Microbiol. 2018, 200, 1439–1445. [Google Scholar] [CrossRef] [PubMed]
- Vaidyanathan, R.; Gopalram, S.; Kalishwaralal, K.; Deepak, V.; Pandian, S.R.K.; Gurunathan, S. Enhanced silver nanoparticle synthesis by optimization of nitrate reductase activity. Colloids Surf. B Biointerfaces 2010, 75, 335–341. [Google Scholar] [CrossRef]
- Gopinath, V.; Velusamy, P. Extracellular biosynthesis of silver nanoparticles using Bacillus sp. Gp-23 and evaluation of their antifungal activity towards fusarium oxysporum. Spectrochim. Acta A Mol. Biomol. Spectrosc. 2013, 106, 170–174. [Google Scholar] [CrossRef] [PubMed]
- Galán, J.E. Salmonella Typhimurium and inflammation: A pathogen-centric affair. Nat. Rev. Microbiol. 2021, 19, 716–725. [Google Scholar] [CrossRef] [PubMed]
- Raymond, P.; Houard, E.; Denis, M.; Esnault, E. Diversity of Yersinia enterocolitica isolated from pigs in a French slaughterhouse over 2 years. MicrobiologyOpen 2019, 8, e00751. [Google Scholar] [CrossRef] [PubMed]
- Nair, D.V.T.; Venkitanarayanan, K.; Johny, A.K. Antibiotic-Resistant Salmonella in the Food Supply and the Potential Role of Antibiotic Alternatives for Control. Foods 2018, 7, 167. [Google Scholar] [CrossRef]
- Younis, G.; Mady, M.; Awad, A. Yersinia enterocolitica: Prevalence, virulence, and antimicrobial resistance from retail and processed meat in Egypt. Vet. World 2019, 12, 1078–1084. [Google Scholar] [CrossRef]
- Sheu, S.Y.; Su, C.L.; Kwon, S.W.; Chen, W.M. Flavobacterium amniphilum sp. nov., isolated from a stream. Int. J. Syst. Evol. Microbiol. 2017, 67, 5179–5186. [Google Scholar] [CrossRef]
- Weisburg, W.G.; Barns, S.M.; Pelletier, D.A.; Lane, D.J. 16S ribosomal DNA amplification for phylogenetic study. J. Bacteriol. 1991, 173, 697–703. [Google Scholar] [CrossRef]
- Yoon, S.H.; Ha, S.M.; Kwon, S.; Lim, J.; Kim, Y. Introducing EzBioCloud: A taxonomically united database of 16S rRNA gene sequences and whole-genome assemblies. Int. J. Syst. Evol. Microbiol. 2017, 67, 1613–1617. [Google Scholar] [CrossRef]
- Tamura, K.; Stecher, G.; Peterson, D.; Filipski, A.; Kumar, S. MEGA6: Molecular evolutionary genetics analysis version 6.0. Mol. Biol. Evol. 2013, 30, 2725–2729. [Google Scholar] [CrossRef]
- Felsenstein, J. Confidence limits on phylogenies: An approach using the bootstrap. Evolution 1985, 39, 783–791. [Google Scholar] [CrossRef]
- Meier-Kolthoff, J.P.; Auch, A.F.; Klenk, H.P.; Göker, M. Genome sequence-based species delimitation with confidence intervals and improved distance functions. BMC. Bioinform. 2013, 14, 60. [Google Scholar] [CrossRef]
- Aziz, R.K.; Bartels, D.; Best, A.A.; DeJongh, M.; Disz, T.; Edwards, R.A.; Formsma, K.; Gerdes, S.; Glas, E.M.; Kubal, M. The RAST server: Rapid annotations using subsystems technology. BMC Genome 2008, 9, 1–15. [Google Scholar] [CrossRef]
- Sasser, M. Identification of Bacteria by Gas Chromatography of Cellular Fatty Acids; MIDI Technical Note 101; MIDI Inc.: Newark, DE, USA, 1990. [Google Scholar]
- Collins, M.D. Isoprenoid quinones. In Chemical Methods in Prokaryotic Systematics Chichester; Goodfellow, M., O’Donnell, A.G., Eds.; Wiley: Hoboken, NJ, USA, 1994; pp. 265–309. [Google Scholar]
- Du, J.; Sing, H.; Yi, T.H. Biosynthesis of silver nanoparticles by Novosphingobium sp. THG-C3 and their antimicrobial potential. Artif. Cells Nanomed. Biotechnol. 2017, 45, 211–217. [Google Scholar] [CrossRef]
- Ansari, M.A.; Baykal, A.; Asiri, S. Synthesis and characterization of antibacterial activity of spinel chromium-substituted copper ferrite nanoparticles for biomedical application. J. Inorg. Organomet. Polym. Mater. 2018, 28, 2316–2327. [Google Scholar] [CrossRef]
- Shi, W.; Sun, Q.; Fan, G.; Hideaki, S.; Moriya, O.; Itoh, T.; Zhou, Y.; Cai, M.; Kim, S.G.; Lee, J.S. gcType: A high-quality type strain genome database for microbial phylogenetic and functional research. Nucleic Acids Res. 2021, 49, D694–D705. [Google Scholar] [CrossRef]
- Huq, M.A. Green Synthesis of Silver Nanoparticles Using Pseudoduganella eburnean MAHUQ-39 and Their Antimicrobial Mechanisms Investigation against Drug Resistant Human Pathogens. Int. J. Mol. Sci. 2020, 21, 1510. [Google Scholar] [CrossRef]
- Zhang, X.F.; Liu, Z.G.; Shen, W.; Gurunathan, S. Silver nanoparticles: Synthesis, characterization, properties, applications, and therapeutic approaches. Int. J. Mol. Sci. 2016, 17, 1534. [Google Scholar] [CrossRef] [PubMed]
- Ganesh-Babu, M.M.; Gunasekaran, P. Production and structural characterization of crystalline silver nanoparticles from Bacillus cereus isolate. Colloids Surf. B Biointerfaces 2009, 74, 191–195. [Google Scholar] [CrossRef] [PubMed]
- Singh, N.; Khanna, P.K. In situ synthesis of silver nano-particles in polymethylmethacrylate. Mater. Chem. Phys. 2007, 104, 367–372. [Google Scholar] [CrossRef]
- Dong, Z.Y.; Rao, N.; Prabhu, M.; Xiao, M.; Wang, H.F.; Hozzein, W.N.; Chen, W.; Li, W.J. Antibacterial activity of silver nanoparticles against Staphylococcus warneri synthesized using endophytic bacteria by photo-irradiation. Front. Microbiol. 2017, 8, 1090. [Google Scholar] [CrossRef] [PubMed]
- Singh, P.; Pandit, S.; Jers, C.; Abhayraj, S.; Garnæs, J.; Mijakovic, I. Silver nanoparticles produced from Cedecea sp. exhibit antibiofilm activity and remarkable stability. Sci. Rep. 2021, 11, 12619. [Google Scholar] [CrossRef] [PubMed]
- Shankar, S.; Rhim, J.W. Amino acid mediated synthesis of silver nanoparticles and preparation of antimicrobial agar/silver nanoparticles composite films. Carbohydr. Polym. 2015, 130, 353–363. [Google Scholar] [CrossRef] [PubMed]
- Huq, M.A.; Akter, S. Bacterial Mediated Rapid and Facile Synthesis of Silver Nanoparticles and Their Antimicrobial Efficacy against Pathogenic Microorganisms. Materials 2021, 14, 2615. [Google Scholar] [CrossRef] [PubMed]
- Akter, S.; Lee, S.-Y.; Siddiqi, M.Z.; Balusamy, S.R.; Ashrafudoulla, M.; Rupa, E.J.; Huq, M.A. Ecofriendly synthesis of silver nanoparticles by Terrabacter humi sp. nov. and their antibacterial application against antibiotic-resistant pathogens. Int. J. Mol. Sci. 2020, 21, 9746. [Google Scholar] [CrossRef]
- Guo, L.; Gong, S.; Wang, Y.; Sun, Q.; Duo, K.; Fei, P. Antibacterial Activity of Olive Oil Polyphenol Extract Against Salmonella Typhimurium and Staphylococcus aureus: Possible Mechanisms. Foodborne Pathog. Dis. 2020, 17. [Google Scholar] [CrossRef]
- Hosseinzadeh, S.; Saei, H.D.; Ahmadi, M.; Salehi, T.Z. Antimicrobial effect of Licochalcone A and Epigallocatechin-3-gallate against Salmonella Typhimurium isolated from poultry flocks. Iran. J. Microbiol. 2018, 10, 51–58. [Google Scholar]
- Polinarski, M.A.; Ana, L.B.; Silva, F.E.B.; Bernardi-Wenzel, J. New Perspectives of Using Chitosan, Silver, and Chitosan–Silver Nanoparticles against Multidrug-Resistant Bacteria. Part. Part. Syst. Charact. 2021, 38, 2100009. [Google Scholar] [CrossRef]
- Khan, S.U.; Ansarid, M.J.; Khan, M.H.U. Antimicrobial potentials of medicinal plant’s extract and their derived silver nanoparticles: A focus on honey bee pathogen. Saudi J. Biol. Sci. 2019, 26, 1815–1834. [Google Scholar] [CrossRef]
- Kim, J.S.; Kuk, E.; Yu, K.N. Antimicrobial effects of silver nanoparticles. Nanomed. Nanotechnol. Biol. Med. 2007, 3, 95–101. [Google Scholar] [CrossRef]

| Characteristics | 1 | 2 | 3 | 4 | 5 | 6 |
|---|---|---|---|---|---|---|
| Isolation source | Soil of rice field | Pokkali rice | Sewage | Filtration substrate from trass | Creosote-contaminated soil | Marine sediments |
| Cell morphology | Rod | Rod | Rod–coccus | Rod–coccus | Rod–coccus | Rod–coccus |
| Colony color | Milky white | Yellow | Creamy white | Light yellow | Cream to yellow | Cream to light grey |
| Growth temperature (°C) | 10–40 | 18–37 a | 5–37 b | 5–40 c | 4–37 d | 10–45 e |
| Growth pH | 5.0–10.0 | 5.5–8.0 a | 6.0–10.0 b | 6.0–11.0 c | 6.5–8.5 d | 5.0–9.0 e |
| Hydrolysis of: | ||||||
| Gelatin (API 20 NE) | - | - | - | + | - | - |
| Urea (API 20 NE) | - | - | - | W | - | - |
| Enzyme activity (API ZYM): | ||||||
| Esterase (C4) | + | + | W | + | W | + |
| Alkaline phosphatase | + | + | - | + | W | + |
| Esterase lipase (C8) | W | + | - | + | W | + |
| Acid phosphatase | + | - | + | + | W | - |
| Valine arylamidase | W | + | - | W | W | + |
| Trypsin | + | + | - | + | W | - |
| β-glucuronidase | + | + | + | + | + | - |
| a-glucosidase | + | + | + | + | W | - |
| β-galactosidase | + | + | + | + | W | - |
| a-fucosidase | + | + | + | - | - | - |
| Assimilation of (API 20 NE): | ||||||
| D-glucose | + | - | + | + | - | + |
| D-maltose | + | + | + | - | - | + |
| D-mannose | + | - | + | - | - | + |
| D-mannitol | + | + | + | - | W | - |
| Malic acid | + | + | + | W | W | + |
| DNA G + C content (mol%) | 66.0 | 64.0 a | 64.4 b | 70.8 c | 65.7 d | 61.3 e |
| Features | Strain MAHUQ-56T |
|---|---|
| Accession no. | JAIFZQ000000000 |
| Biosample | SAMN20721218 |
| BioProject | PRJNA754020 |
| Total sequence length (nt) | 4,566,112 |
| Scaffold N50 | 360,503 |
| Scaffold N75 | 196,969 |
| Number of scaffold | 26 |
| Sequencing method | de novo (illumina XTen) |
| Annotation pipeline | NCBI Prokaryotic Genome |
| DNA G + C content (mol%) | 66.0 |
| Total genes | 4233 |
| Genes (coding) | 4125 |
| Number of RNAs | 60 |
| tRNAs | 51 |
| rRNAs | 6 |
| Fatty Acid | 1 | 2 | 3 | 4 | 5 | 6 |
|---|---|---|---|---|---|---|
| C14:0 | 2.3 | 1.4 | 1.5 | 1.3 | 1.6 | 2.0 |
| C14.0 iso | 3.5 | 1.6 | 3.4 | 1.5 | ND | 2.2 |
| C15:0 iso | 11.9 | 8.1 | 13.8 | 7.8 | 15.1 | 14.5 |
| C15:0 anteiso | 47.8 | 54.5 | 55.6 | 52.0 | 37.7 | 48.3 |
| C16:1 w7c | ND | ND | ND | ND | 2.6 | ND |
| C16:0 iso | 15.8 | 8.5 | 11.9 | 12.2 | 16.0 | 11.2 |
| C16:0 | 3.8 | 7.2 | 4.0 | 6.0 | 7.9 | 6.2 |
| C17:0 iso | 1.6 | 1.5 | 1.1 | 2.0 | 4.2 | 2.0 |
| C17:0 anteiso | 11.7 | 13.8 | 5.9 | 13.9 | 13.1 | 11.3 |
| Element | Weight % | Atomic % |
|---|---|---|
| Cu K | 50.66 | 63.54 |
| Ag L | 49.34 | 36.46 |
| Totals | 100.00 | 100.00 |
| Pathogenic Species | Zone of Inhibition (mm) | |
|---|---|---|
| AgNPs (30 μL) | AgNPs (60 μL) | |
| Salmonella Typhimurium (ATCC 14028) | 11.5 ± 0.5 | 18.3 ± 0.6 |
| Yersinia enterocolitica (ATCC 9610) | 13.5 ± 0.7 | 20.4 ± 0.8 |
| Pathogenic Species | MIC (μg/mL) | MBC (μg/mL) |
|---|---|---|
| Salmonella Typhimurium (ATCC 14028) | 6.2 | 12.5 |
| Yersinia enterocolitica (ATCC 9610) | 3.1 | 12.5 |
Publisher’s Note: MDPI stays neutral with regard to jurisdictional claims in published maps and institutional affiliations. |
© 2021 by the authors. Licensee MDPI, Basel, Switzerland. This article is an open access article distributed under the terms and conditions of the Creative Commons Attribution (CC BY) license (https://creativecommons.org/licenses/by/4.0/).
Share and Cite
Huq, M.A.; Akter, S. Characterization and Genome Analysis of Arthrobacter bangladeshi sp. nov., Applied for the Green Synthesis of Silver Nanoparticles and Their Antibacterial Efficacy against Drug-Resistant Human Pathogens. Pharmaceutics 2021, 13, 1691. https://doi.org/10.3390/pharmaceutics13101691
Huq MA, Akter S. Characterization and Genome Analysis of Arthrobacter bangladeshi sp. nov., Applied for the Green Synthesis of Silver Nanoparticles and Their Antibacterial Efficacy against Drug-Resistant Human Pathogens. Pharmaceutics. 2021; 13(10):1691. https://doi.org/10.3390/pharmaceutics13101691
Chicago/Turabian StyleHuq, Md. Amdadul, and Shahina Akter. 2021. "Characterization and Genome Analysis of Arthrobacter bangladeshi sp. nov., Applied for the Green Synthesis of Silver Nanoparticles and Their Antibacterial Efficacy against Drug-Resistant Human Pathogens" Pharmaceutics 13, no. 10: 1691. https://doi.org/10.3390/pharmaceutics13101691
APA StyleHuq, M. A., & Akter, S. (2021). Characterization and Genome Analysis of Arthrobacter bangladeshi sp. nov., Applied for the Green Synthesis of Silver Nanoparticles and Their Antibacterial Efficacy against Drug-Resistant Human Pathogens. Pharmaceutics, 13(10), 1691. https://doi.org/10.3390/pharmaceutics13101691
